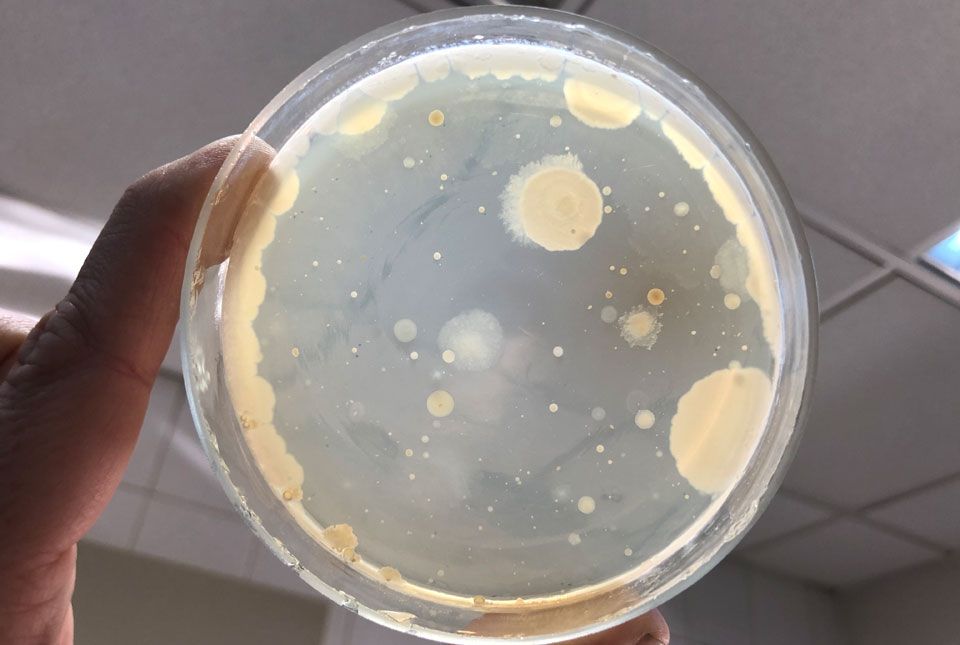
Ne idd meg!

Ne idd meg!
A szejkei borvízforrásban rendszeresen találnak emberiürülék-eredetű baktériumokat. Emésztőrendszeri és húgyúti betegségeket okozhatnak. Újratervezés szükséges.

Fotó: DR. MÁTHÉ ISTVÁN
Újabb higiéniai-mikrobiológiai vizsgálatokat végeztek január végén a Sapientia Erdélyi Magyar Tudományegyetem laboratóriumaiban dr. Máthé István, a csíkszeredai biomérnöki tanszék oktatójának vezetésével. Január 25-én a szejkei borvízforrásból is vettek vízmintákat, elemezve azok fogyaszthatóságát.
Az eredmények alapján megállapítható, hogy a januári vízmintákban több mint ötször magasabb a baktériumok összcsíraszáma 22 Celsius fokon (528 baktérium/1 milliliter vízminta), mint az ivóvizekre vonatkozó maximális határték. Elsősorban a melegvérű állatoktól vagy embertől származó, 37 Celsius fokon kitenyészthető baktériumok csíraszáma tízszerese a határértéknek (203 baktérium/1 ml minta). Ugyanakkor a szejkei forrásból kimutathatóak voltak úgynevezett coliform baktériumok (28 telep/100 ml) és anaerob spórás szulfit-redukáló baktériumok (ún. Clostridium fajok), amely mikrobacsoportok a hatályos törvények szerint nem lehetnek jelen ivóvizekben.
“Pár nappal a vizsgálatunkat megelőzően megjelent a sajtóban, hogy újra iható a szejkei forrás vize, de az sajnos a havazásnak és hóolvadásnak köszönhetően rövid időn belül újra beszennyeződött. A januári mikrobiológiai vizsgálatunk összegezéseképpen elmondható, hogy a főút melletti szejkei forrás vize nem iható minőségű” – áll dr. Máthé István által szerkesztőségünkbe eljuttatott közleményében.
A tenyésztéses és DNS vizsgálatok során kimutatott baktériumcsoportok a szakirodalom alapján elsősorban gyomor- és bélgyulladást okozhatnak, nagyon legyengült immunrendszerű (általában krónikus betegségben szenvedő) embereknél pedig további húgyúti-, légúti-, sebfertőzéseket stb. is előidézhetnek.
Az eredmények megerősítik a tavalyi vizsgálataik végkövetkeztetését, hogy a főút melletti szejkei forrás vize erőteljesen ki van téve a felszíni beszennyeződés lehetőségének, nem elegendő az időszakos fertőtlenítés, ezért teljesen újra kellene gondolni a forrásfoglalást, és gyakrabban bevizsgáltatni a szejkei borvízforrás minőségét.





